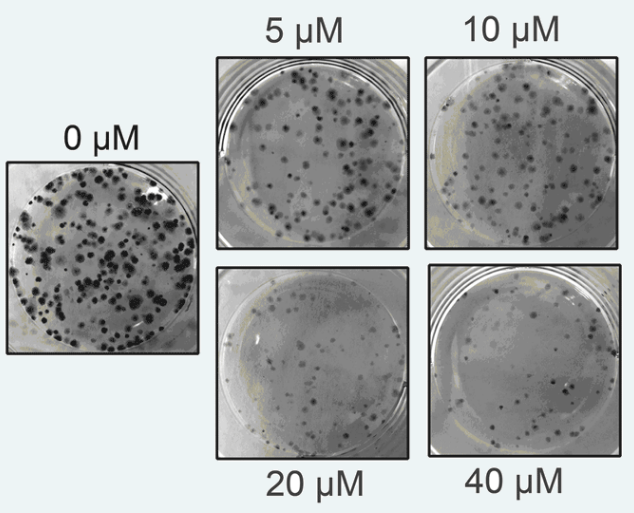

细胞增殖实验服务
细胞增殖是生物体生长、发育、繁殖、遗传的基础,是细胞最基本的生理活动。生长因子、激素及癌基因产物等均可诱导细胞的增殖或抑制细胞的增殖,通过影响细胞周期、诱导细胞凋亡而实现。
客户需提供:
1、初步实验方案
2、目的细胞或目的细胞信息
3、实验分组及方案确认
实验室将完成:
1、细胞预实验:确保实验可以按照设计方案进行
2、实验检测:根据预实验数据和客户要求进行正式实验
3、实验报告:提供原始数据和数据分析结果
MTT检测细胞增殖
MTT全称为3-(4,5)-dimethylthiahiazo (-z-y1)-3,5-di-phenytetrazoliumromide。MTT比色法是常用的检测细胞存活和生长的方法之一,其检测原理为活细胞线粒体中的琥珀酸脱氢酶能使外源性MTT 还原为水不溶性的蓝紫色结晶甲瓒并沉积在细胞中,而死细胞无此功能。二甲基亚砜能溶解细胞中的甲瓒,用酶标仪在490nm波长处测定其光吸收值,在一定细胞数范围内,甲瓒结晶形成的量与细胞数成正比,因此490nm波长处的吸光值可间接反映活细胞数量。该方法已广泛用于抗肿瘤药物筛选、细胞毒性试验以及肿瘤放射敏感性测定等。
实验实例:
向96孔板每孔加入2000个细胞培养过夜,用不同浓度药物处理细胞24 h和48 h,向孔板中加入MTT溶液,孵育4h。最后去除MTT,加入二甲基亚砜溶解,酶标仪读取OD490时的吸光值,计算存活率。

结论:加药处理后,细胞生长受到抑制。
基本收费:可根据具体实验项目协商收费。
克隆形成实验
是测定细胞的增殖能力的有效方法之一。单个细胞在体外持续6代以上,其后代所组成的细胞群称为克隆。这时每个克隆含有50个以上的细胞,大小在0.3~1.0mm之间,通过计数克隆形成率,可对单个细胞的增殖潜力做定量分析,了解细胞的增殖能力和独立生存能力。
应用实例
平板克隆形成:在6孔板中接种500个细胞/孔,用不同浓度药物处理细胞48 h,更换新鲜培养基静置培养2周左右,中途隔3天换液并观察细胞状态,出现肉眼可见的克隆即终止培养,用多聚甲醛固定1h,再用台盼蓝染色并计数。得到的实验结果如下:
实验结论:药物处理后细胞克隆形成能力减弱。
基本收费:可根据具体实验项目协商收费。
细胞周期
细胞周期指细胞一代所经历的时间。从一次细胞分裂结束到下一次分裂结束为一个周期。细胞周期反应了细胞增殖速度。细胞周期检测最常用的是PI渗入测定细胞周期。PI,即碘化丙锭,可以与细胞内DNA 和RNA 结合,采用RNA酶将RNA消化后,通过流式细胞术检测到的与DNA 结合的PI 的荧光强度直接反映细胞内DNA含量的多少。由于细胞周期各时相的DNA 含量不同,通常正常细胞的 G0/G1 期具有二倍体细胞的DNA 含量(2N),而G2/ M 期具有四倍体细胞的DNA 含量(4N),而S 期的DNA含量介于二倍体和四倍体之间。因此,通过流式细胞术PI染色法对细胞内DNA 含量进行检测时,可以将细胞周期各时相区分为 G0/G1 期,S 期和G2/ M 期,并可通过软件计算各时相的百分率。
应用实例
同一药物浓度分别处理细胞24 h和48 h,洗涤消化并用预冷的70% 乙醇溶液固定细胞过夜,PI染色,流式细胞仪检测,得到的周期实验结果如下:

实验结论:药物处理细胞后,处于G2期的细胞显著增加,处于G1期的细胞显著减少,提示药物影响细胞的周期分布。
基本收费:可根据具体实验项目协商收费。
细胞凋亡
是指细胞在一定的生理或病理条件下,遵循自身的程序,自己结束其生命的过程。它是一个主动的,高度有序的,基因控制的,一系列酶参与的过程。通常使用Annexin V/PI双染法检测细胞凋亡,该法省时,简单,结果可靠,可区分早期与晚期凋亡,是目前最为常用的检测细胞凋亡的方法。
应用实例
药物处理细胞12 h、24 h和48 h后,消化并收集细胞,用PBS洗涤细胞三次,加入Annexin V和PI双染,流式细胞仪检测。

实验结论:药物处理细胞后,随着处理时间的延长,凋亡细胞显著增加。
咨询
- 610
- 点赞
- 复制链接
- 举报
